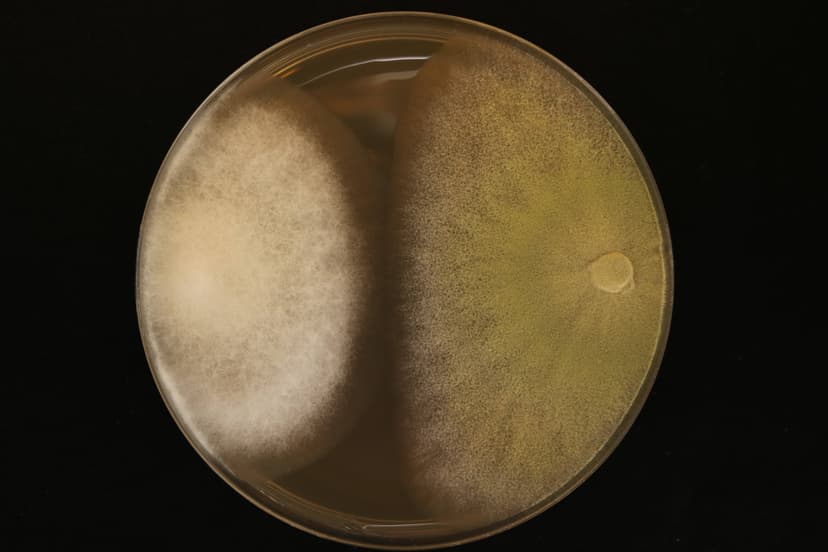

El maíz, un cultivo altamente sensible a las variaciones ambientales, enfrenta desafíos significativos en Argentina y Colombia debido al cambio climático. El incremento de las temperaturas y las alteraciones en los patrones de precipitación han intensificado las sequías, desplazado los ciclos de siembra y cosecha y fomentado la proliferación de plagas y enfermedades que merman los rendimientos. Adicionalmente, las técnicas agrícolas tradicionales continúan degradando la calidad y fertilidad del suelo, comprometiendo la absorción de nutrientes esenciales para el desarrollo óptimo de las plantas. Esta situación ha obligado a los agricultores a incrementar el uso de insumos agrícolas, muchos de los cuales son importados, elevando considerablemente los costos de gestión fitosanitaria.
Este proyecto se dirige al sector productivo del maíz, resaltando su papel crítico en la seguridad alimentaria mundial ante la creciente demanda y la necesidad de adaptación al cambio climático. La propuesta tecnológica se centra en el uso de bioinsumos, explotando el potencial de los microorganismos nativos como biofertilizantes, biocontroladores y bioestimulantes para mejorar la sostenibilidad del cultivo. La implementación de estas especies favorece la colonización del hábitat, optimiza la estructura del suelo y el flujo de nutrientes, y mejora la resistencia a estreses bióticos y abióticos.
Este enfoque no solo busca incrementar la eficiencia del cultivo de maíz sino también expandir la aplicabilidad de los bioproductos a otros sectores agrícolas. Asimismo, se desarrollarán estrategias de gestión y transferencia de conocimiento, colaborando estrechamente con productores y entidades académicas y gubernamentales en los países involucrados, para asegurar la adopción y el impacto positivo de estas tecnologías en la agricultura.
Se avanzó en la caracterización genómica de Beauveria bassiana (Bv064) y Metarhizium robertsii (Mt015), y en la evaluación de eficacia de cepas nativas en Colombia y Argentina. En Colombia, Bv064 y Mtcatol2 superaron el 40 % de eficacia frente a plagas clave del maíz. En Argentina, M. anisopliae (Ma1) alcanzó 62 % contra S. frugiperda. Trichoderma Th406, Th008 y Th032 destacaron en Colombia frente a Macrophomina, Stenocarpella y Fusarium spp.; TH1, TH2 y Tbr1 sobresalieron en Argentina contra cepas locales de F. oxysporum. Se definió con AgResearch (NZ) una metodología de fraccionamiento de agregados para cuantificar carbono estable en suelos. Se avanzó en la producción de HFMA y pruebas con plantas trampa en Colombia y Argentina. Se realizaron más de 20 reuniones de coordinación y 4 talleres con actores locales, destacando un workshop binacional y capacitaciones a pequeños productores en manejo biológico.
Los resultados preliminares muestran un alto potencial de hongos nativos para el control biológico de plagas y patógenos, avances en métodos de captura de carbono en suelo y actividades exitosas de capacitación a pequeños productores.
.jpg&w=3840&q=100)
.jpg&w=3840&q=100)